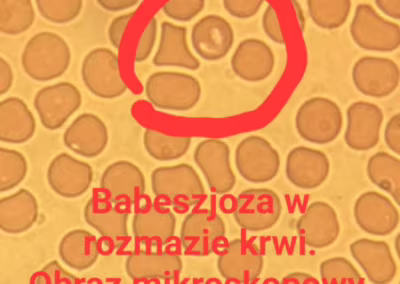

Chcemy przypomnieć o niebezpiecznym wrogu naszych pupili – kleszczu.
Kilka dni temu trafił do naszej lecznicy Monte.
Jego opiekun zauważył niepokojące objawy.
Piesek stał się apatyczny, stracił apetyt i co jest bardzo specyficzne oddawał bardzo ciemny mocz.
Badania krwi – morfologia oraz rozmaz w obrazie mikroskopowym wykazały, że jest to babeszjoza – groźna choroba przenoszona przez kleszcze.
Po kilku dniach intensywnego leczenia Monte wyzdrowiał. 

 i chyba nas polubił, bo cieszy się na nasz widok przychodząc na wizyty kontrolne
i chyba nas polubił, bo cieszy się na nasz widok przychodząc na wizyty kontrolne 
Pamiętajcie, że pomimo zimy kleszcze nie śpią więc zabezpieczajcie odpowiednio swoje pociechy. 

Cały nasz zespół pozdrawia serdecznie